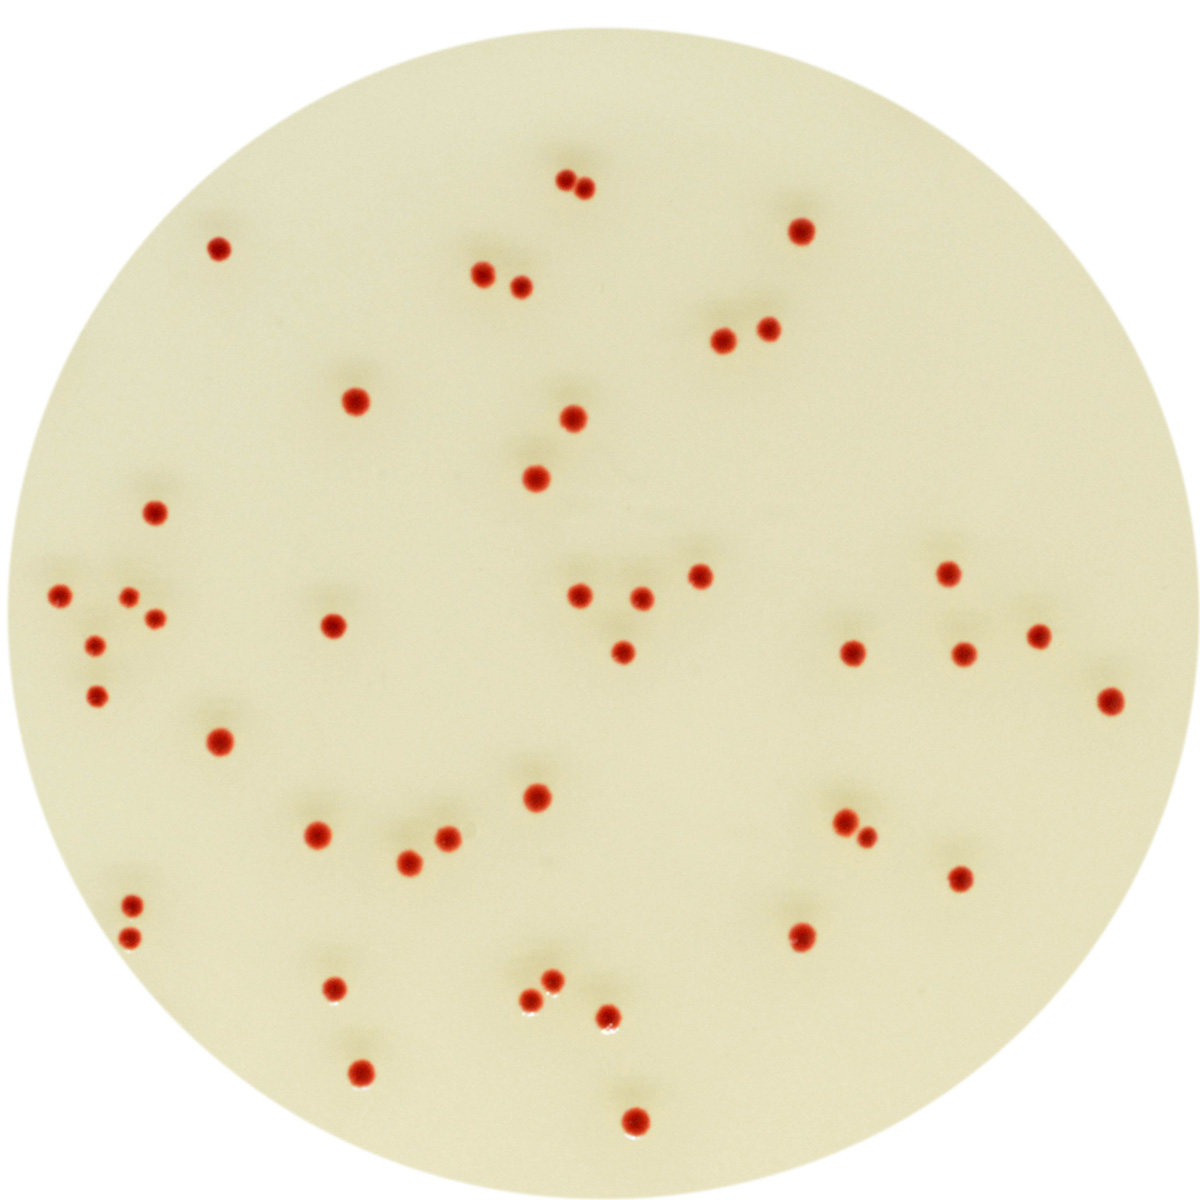
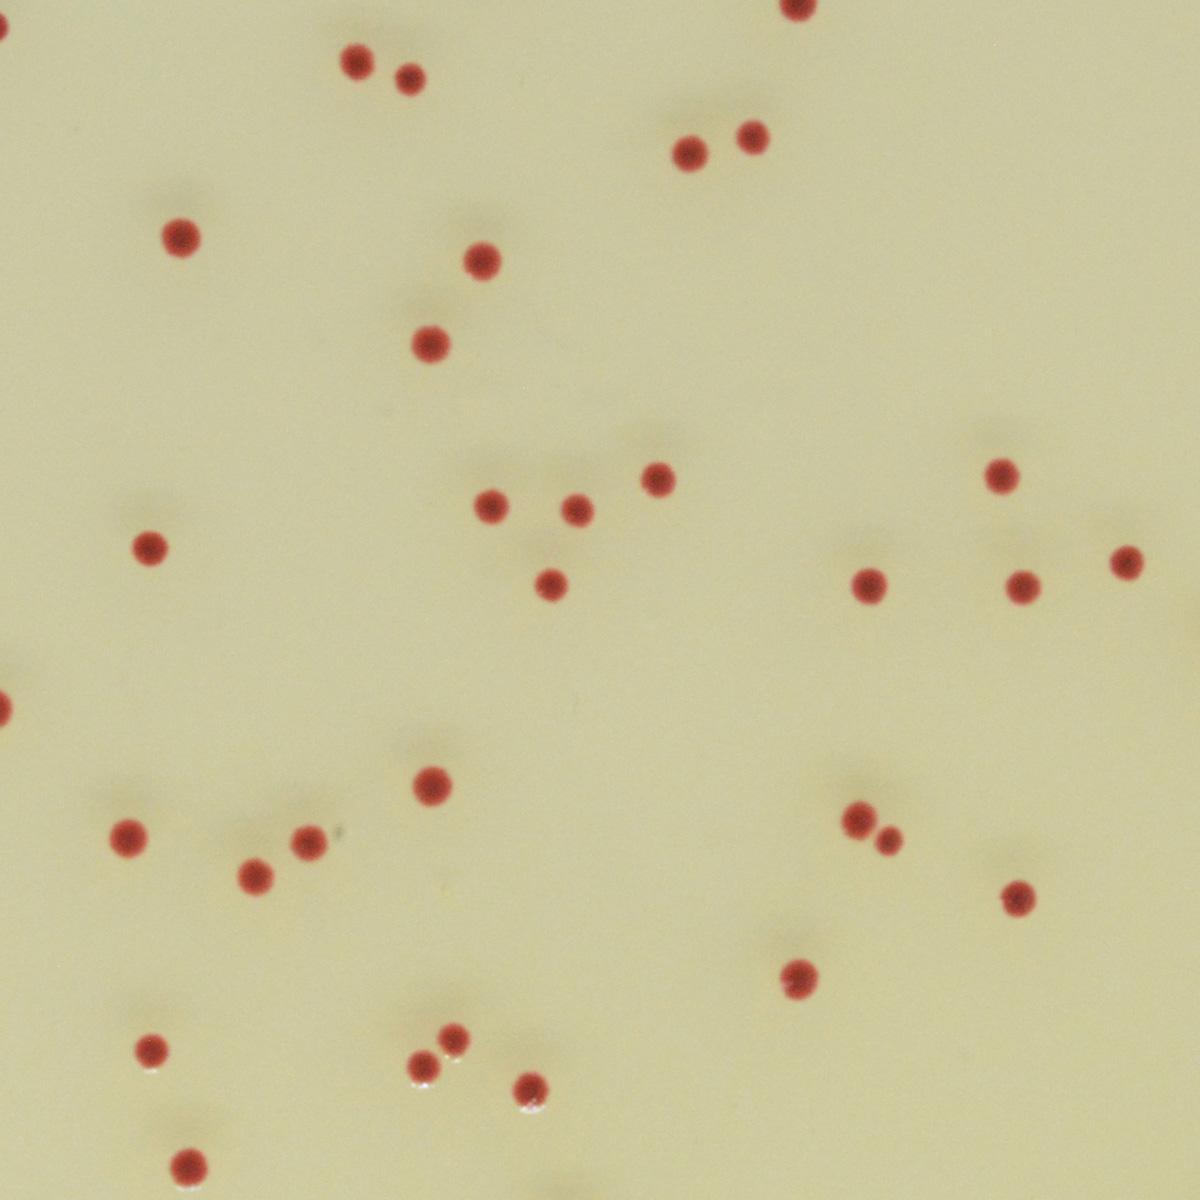

À propos du produit
Milieu chromogène sélectif pour l’isolement et le dénombrement de Campylobacter thermotolérant.
CHROMAGAR CAMPYLOBACTER

Milieu chromogène sélectif pour l’isolement et le dénombrement de Campylobacter thermotolérant.